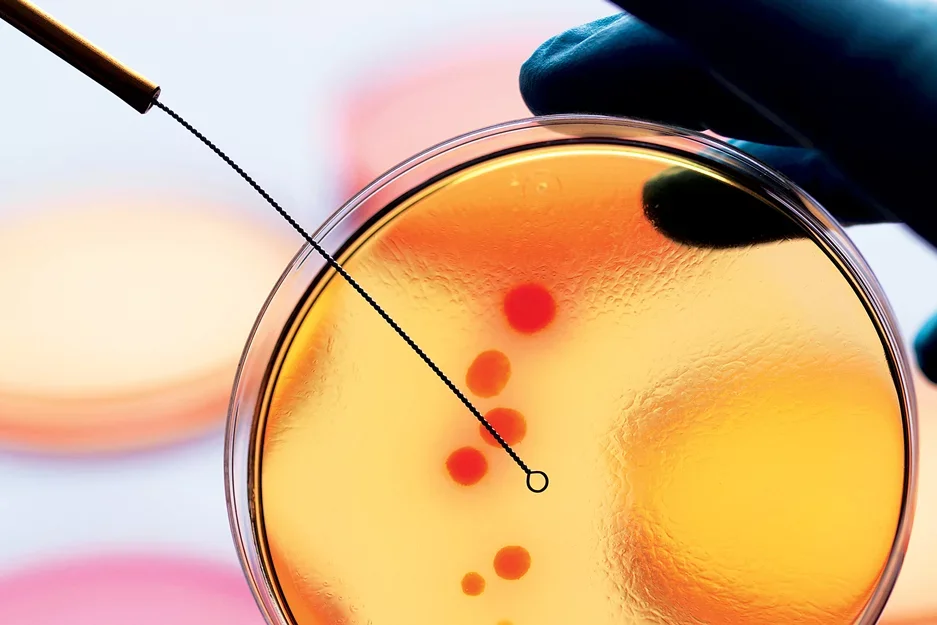
A petrie dish with yellow and red liquid

Enhancing Immune Responses
Can We Enhance The Immune Response To Help People Heal?

Genhong Cheng, PhD
Professor, Microbiology, Immunology and Molecular Genetics at UCLA
Member, California NanoSystems Institute
Defining The Immune Response
Dr. Genhong Cheng believes we can learn how to heal patients by studying the undisputed experts of disease defense: immune system cells. He has illuminated many secrets of nature's immunological "art of war," the evolutionary mechanisms that enable our bodies to mobilize strategic, balanced attacks against invaders.
Dr. Cheng follows the independent processes of innate and adaptive immunity, and he also investigates how and why the two systems sometimes work together. He aims to define the processes underlying:
- Balanced immune responses and optimal outcomes
- Faulty immune responses that allow infection
- Overzealous immune responses that trigger inflammation
Dr. Cheng wants to help patients achieve a "just right" reaction to any threat, avoiding the systemic flaws leading to infection or chronic inflammation.
Enhancing The Human Immune Response
Dr. Cheng’s studies lead to diverse findings with applications in a range of diseases, from HIV to cancer. Through his research, Dr. Cheng creates a constellation of disparate insights he hopes to one day connect to create a master disease-fighting map.
Discovery: A naturally occurring molecule inhibits viruses, including HIV.
Dr. Cheng and his team discovered a protein that converts cholesterol to create a molecule, 25-hydroxycholesterol (25HC), with remarkable antiviral properties. The team observed the molecule blocking viral cell entry, suppressing viral replication, and halting T-cell depletion.
Implication: An enhanced, synthesized version of the molecule protects against Zika infection.
Read more in 25-Hydroxycholesterol Protects Host against Zika Virus Infection and Its Associated Microcephaly in a Mouse Model, published in Immunity.
Discovery: Blocking an immune helper stops chronic inflammation and lets the immune system fight infection.
When faced with infection, type I interferons (IFN-I) signal for attack, facilitating immune cell communication and mobilization. Their efforts are generally helpful, but in persistent infections, their constant attack signals can exhaust an immune system and lead to inflammation. When Dr. Cheng and his team experimented with blocking IFN-I, they noted a decrease in inflammation and an increase in the efficacy of immune attack.
Implication: The finding provided a foundation for designing IFN-I blockade therapies to treat chronic infection.
Read more in Blockade of Chronic Type I Interferon Signaling to Control Persistent LCMV Infection, published in Science.
Discovery: There might be a link between inflammation and cancer.
Dr. Cheng and his team determined that a gene-regulating micro RNA (miR-155) plays a role in early immune responses to inflammatory mediators. Combining this observation with existing evidence linking miR-155 to the development of cancer tumors, the researchers hypothesized a link between cancer and inflammation.
Implication: The team’s finding opened doors for subsequent studies solidifying the link between inflammation and cancer. It also created a basis for developing and testing miR-155-based cancer treatments and immunotherapies.
Read more in MicroRNA-155 is Induced During the Macrophage Inflammatory Response, published in the Proceedings of the National Academy of Science.
Learn more about the Department of Microbiology, Immunology and Molecular Genetics (MIMG)
The Future of Immune System Enhancement
Dr. Cheng cannot wait to see what else he can learn to inform his mission to mimic—and enhance—our natural weaponry and improve human health in immeasurable ways. Dr. Cheng recently helped identify an immune molecule that inhibits Zika infection and associated birth defects, and he’s currently working on a National Institutes of Health study examining the immune system's role in radiation-induced diseases.
What other health secrets can we learn from studying the immune system? Dr. Cheng is determined to find out.